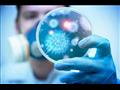
فيروس كورونا

مركز أمريكي: 40% من مصابي كورونا ينقلون العدوى قبل ظهور أعراض
كتب : مصراوي
فيروس كورونا
وكالات:
أكدت مراكز السيطرة على الأمراض والوقاية منها الأمريكية (CDC)، أن 35% نحو ثلث مرضى فيروس كورونا لا تظهر عليهم أعراض.
وأضافت أن نسبة 0.4% من المصابين وتظهر عليهم الأعراض ستتسبب حالتهم بالوفاة، وقدّر المركز أن نسبة 40% من انتقال عدوى فيروس كورونا المستجد تحدث قبل ظهور أعراض المرض على الشخص المصاب.
وأوضح المركز أن هذه الأرقام عرضة للتغيير، بينما يتم معرفة المزيد حول مرض فيروس كورونا، وحذر من أن هذه المعلومات مخصصة لأغراض التخطيط للإجراءات المتعلقة بالصحة العامة. ومع ذلك، فإن تقديراتها تستند إلى بيانات حقيقية جُمعت قبل 29 أبريل الماضي.
وتعد هذه الأرقام جزء من خمسة سيناريوهات للتخطيط "يتم استخدامها من قبل النماذج الحسابية في جميع أنحاء الحكومة الفيدرالية"، وتمثل أربعة من تلك السيناريوهات "الحدود الأدنى والأعلى لمقياس شدة المرض ومدى انتقال الفيروس"، وفقاً لمراكز الأمريكية لمكافحة الأمراض والوقاية منها.
وبالنسبة للأشخاص الذين يبلغون من العمر 65 عاماً وأكثر، فإن مراكز السيطرة على الأمراض تقدر ارتفاع النسبة إلى 1.3%. أما بالنسبة للأشخاص الذين تبلغ أعمارهم 49 عامًا وأقل، فتقدّر مراكز السيطرة على الأمراض أن نسبة 0.05% من الأشخاص المصابين بفيروس كورونا، وتظهر عليهم الأعراض، ستؤدي حالتهم إلى الوفاة.
وتحت أشد السيناريوهات الخمسة، فإن معدل وفاة الحالات التي تظهر عليها الأعراض هو 0.01، ما يعني أن نسبة 1% من الأشخاص المصابين بفيروس كورونا وتظهر عليهم الأعراض سيموتون.
أما في السيناريو الأقل حدة، تُقدّر مراكز السيطرة على الأمراض النسبة بـ 0.2%.
وسرعان ما عارض أحد الخبراء تقديرات مراكز السيطرة على الأمراض، إذ قال عالم الأحياء بجامعة واشنطن، كارل بيرغستروم، لـ CNN إنه في حين أن "غالبية هذه الأرقام معقولة، فإن معدلات الوفيات منخفضة للغاية".
وأوضح بيرغستروم، وهو خبير في النمذجة والمحاكاة الحاسوبية، أن الأرقام تبدو غير متناسقة مع النتائج الواقعية.
وقال بيرغستروم: "تقديرات الأعداد المصابة في مناطق مثل مدينة نيويورك بعيدة كل البعد عن هذه التقديرات. ودعونا نتذكر أن عدد الوفيات في مدينة نيويورك الآن أكبر بكثير مما نتوقعه إذا أصيب جميع البالغين والأطفال في المدينة بفيروس شبيه بالإنفلونزا. وهذه ليست الإنفلونزا، إنه فيروس كورونا".
وعن أرقام مراكز مكافحة الأمراض والوقاية منها، يرى بيرغستروم أن "أفضل تقدير" يعد متفائلاً للغاية، بينما سيناريو" أسوأ الإحتمالات"متفائل إلى حد ما حتى كأفضل تقدير. ومن المؤكد أن المرء يريد النظر في سيناريوهاتٍ أسوأ".
ومن خلال تقديمها كمعايير رسمية لجهود النمذجة، تؤثر أرقام مراكز السيطرة على الأمراض على النماذج التي تنتجها الوكالات الفيدرالية، وسيكون لها تأثير على الخطاب العلمي الأوسع لأنه سيكون هناك بعض الضغط لاستخدام تلك المعايير في أوراق النمذجة للمضي قدماً، وبالنظر إلى أن هذه المعايير تضع تقديراً أقل للوفيات بهامش كبير مقارنة بالإجماع العلمي الحالي، فإن هذا يشكل مُعضلة، وفقاً لما ذكره بيرغستروم.
الأرقام لأغراض التخطيط
وتقول مراكز مكافحة الأمراض والوقاية منها: "تهدف السيناريوهات إلى تعزيز الإستعداد والتخطيط لإجراءات الصحة العامة. فهي ليست تنبؤات أو تقديرات للتأثير المتوقع لفيروس كورونا".
كما توضح مراكز مكافحة الأمراض والوقاية منها أن الأرقام "لا تعكس تأثير أي تغييرات سلوكية، أو التباعد الاجتماعي، أو تدخلات أخرى"، والتي قد تتصل ببعض التقديرات.
ومع ذلك، فإن مراكز السيطرة على الأمراض تصف الأرقام بأنها تقديرات أولية من الوكالات الفيدرالية، و"المصممة للمساعدة في الإبلاغ عن القرارات التي يتخذها مسؤولو الصحة العامة الذين يستخدمون النمذجة الحسابية".
ووفقاً لسيناريو "أفضل تقدير"، تشير التقديرات إلى أن 3.4% من الأشخاص المصابين بفيروس كورونا وتظهر عليهم الأعراض سيحتاجون إلى دخول المستشفى، مع ارتفاع هذا الرقم إلى نسبة 7.4% لدى الأشخاص الذين يبلغون من العمر 65 عاماً وأكثر.
كما تفترض مراكز السيطرة على الأمراض أن الأشخاص المصابين ولا تظهر عليهم أعراض يمكنهم نقل العدوى تماماً مثل أولئك الذين تظهر عليهم الأعراض.